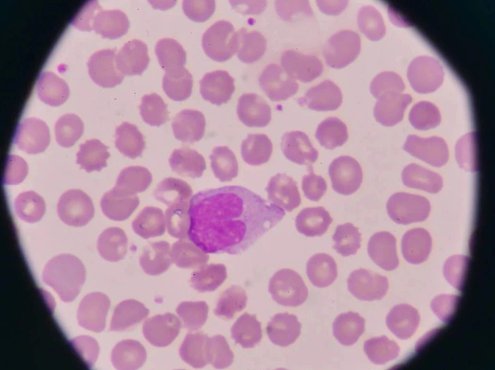
嗜酸性粒细胞升高是怎么回事?

-
嗜酸粒细胞增多症的诊断与鉴别
嗜酸粒细胞增多症的诊断与鉴别 我们先从以下概念说起: ①嗜酸粒细胞增多症:外周血嗜酸粒细胞绝对计数>0.5×109/L。 ②高嗜酸粒细胞增多症(HE):外周血2 次检查(间隔时间>1 个月)嗜酸粒细胞绝对计数>1.5×109/L。根据国际共识,HE分为4种不同类型:继发性(反应性)HE(HER)、原发性(克隆性)HE(HEN)、遗传性(家族性)HE(HEFA)、意义未定(特发性)HE(HEU… -
手把手教你|嗜酸粒细胞增多症的诊断和治疗
定义和分类 1.嗜酸粒细胞增多症(Eosinophilia):外周血嗜酸粒细胞绝对计数>0.5×109/L。 2.高嗜酸粒细胞增多症(HE):外周血2次检查(间隔时间>1个月)嗜酸粒细胞绝对计数>1.5×109/L和(或)骨髓有核细胞计数嗜酸粒细胞比例≥20%和(或)病理证实组织嗜酸粒细胞广泛浸润和(或)发现嗜酸粒细胞颗粒蛋白显著沉积(在有或没有较明显的组织嗜酸粒细胞浸润情况… -
嗜酸性粒细胞增多的 10 大原因,最后一种很容易误诊!
任何原因引起外周血嗜酸粒细胞绝对计数 > 0.5×109/L,即为嗜酸性粒细胞增多症;根据外周血嗜酸性粒细胞绝对值计数,分为以下几种程度: 其常见原因如下: 01生理性变化 正常人嗜酸性粒细胞白天较低,夜间较高。上午波动较大,下午比较恒定。 02变态反应性疾病 可发生轻至中度的嗜酸性粒细胞增多,常见于支气管哮喘、荨麻疹、血管神经性水肿、血清病、花粉症等。 03药物引起 一些药物反应可导致… -
嗜酸粒细胞增多症诊断与治疗中国专家共识(2017年版)
导读为了进一步规范我国血液科医师对嗜酸粒细胞增多症患者的临床诊治,由中华医学会血液学分会白血病淋巴瘤学组牵头,在广泛征求国内专家意见基础上,最终达成了嗜酸粒细胞增多症的诊断程序、实验室检查、诊断标准和治疗原则等方面的共识。 定义和分类 1嗜酸粒细胞增多症(Eosinophilia) 外周血嗜酸粒细胞绝对计数>0.5×109/L。 2高嗜酸粒细胞增多症(Hypereosinophilia, H… -
嗜酸性粒细胞升高是怎么回事?
“我们应该怎么正确解读嗜酸性粒细胞升高? 生活中很多朋友进行血常规检查时出现了嗜酸性粒细胞偏高的情况,常常给生活带来困扰,甚至引发焦虑、恐慌,那么嗜酸性粒细胞升高究竟是怎么回事?我们应该怎么正确解读嗜酸性粒细胞升高? 什么是嗜酸性粒细胞? 嗜酸性粒细胞是粒细胞系统中的重要组成部分,由骨髓干细胞所产生的,嗜酸性粒细胞具有吞噬的作用,可以吞噬多种物质,比如酵母细胞,吞噬抗原、细菌。嗜酸性粒细胞呈圆形,…
❯
个人中心
购物车
优惠劵
今日签到
搜索
扫码打开当前页
返回顶部
幸运之星正在降临...
点击领取今天的签到奖励!
恭喜!您今天获得了{{mission.data.mission.credit}}积分
我的优惠劵
-
¥优惠劵使用时效:无法使用使用时效:
之前
使用时效:永久有效优惠劵ID:×
没有优惠劵可用!